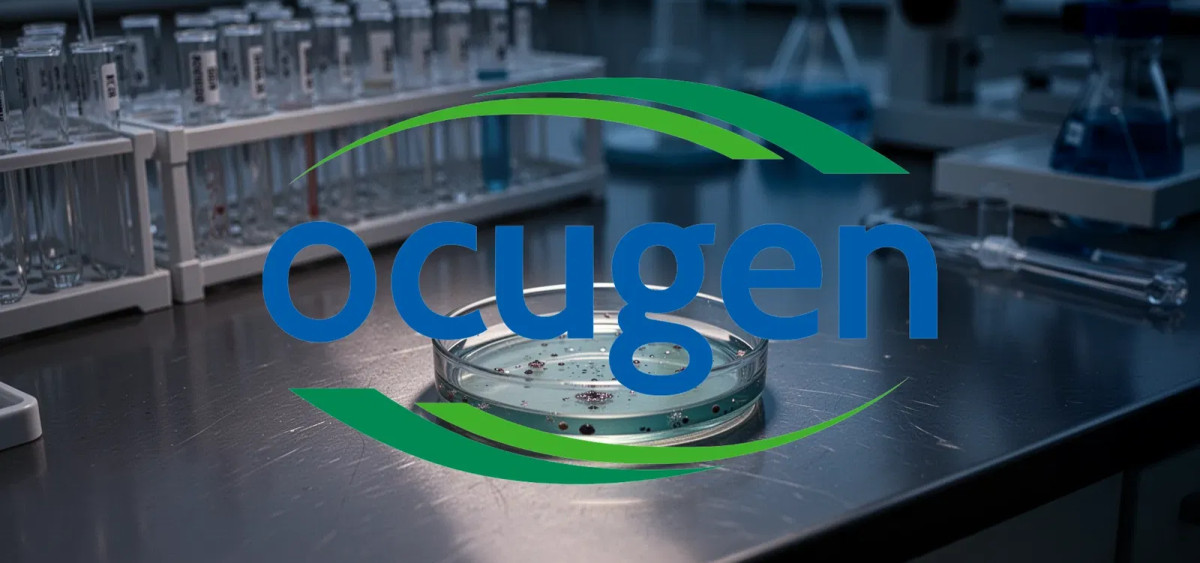
Beitragsbild zu Ocugen Aktie: Rating gesenkt

Ocugen Aktie: Rating gesenkt
Die Ocugen-Aktie gerät unter Druck: Am 9. März 2026 stufte die Research-Firma Wall Street Zen das Papier von „Halten" auf „Verkaufen" herab. Die Begründung: enttäuschende Finanzkennzahlen und ein hartes Wettbewerbsumfeld im Gentherapie- und Impfstoffsektor. Parallel dazu läuft heute eine Lock-up-Frist für bestimmte Aktieneinheiten aus – zusätzlicher Druck für den Kurs.
Verluste ausgeweitet, Liquidität geschrumpft
Die Herabstufung folgt unmittelbar auf die Zahlen für das vierte Quartal und das Gesamtjahr 2025, die Ocugen am 4. März vorlegte. Im Schlussquartal 2025 verzeichnete das Biotech-Unternehmen einen Nettoverlust von 0,06 US-Dollar je Aktie. Auf Jahressicht weitete sich der Verlust auf 0,23 US-Dollar pro Aktie aus.
Besorgniserregender noch: Die Liquidität schmolz deutlich ab. Ende 2025 standen nur noch 18,9 Millionen US-Dollar an Barmitteln in den Büchern – nach 58,8 Millionen im Vorjahr. Um die Finanzierung bis ins vierte Quartal 2026 zu sichern, platzierte Ocugen im Januar 2026 eine Kapitalerhöhung über 22,5 Millionen US-Dollar.
Klinische Pipeline läuft weiter
Trotz der finanziellen Schieflage macht Ocugen bei seinen Entwicklungsprojekten Fortschritte. Die Phase-3-Studie liMeliGhT für OCU400, eine Gen-Modifikationstherapie gegen Retinitis pigmentosa, hat die Rekrutierung von 140 Patienten abgeschlossen. Die Einreichung des Zulassungsantrags ist für das dritte Quartal 2026 geplant, erste Studienergebnisse werden im ersten Quartal 2027 erwartet.
Auch bei OCU410, einem Kandidaten zur Behandlung geografischer Atrophie, zeigen sich positive vorläufige 12-Monats-Daten aus der Phase-2-Studie ArMaDa. Die vollständigen Ergebnisse sollen noch im März veröffentlicht werden. Zudem sicherte sich Ocugen eine exklusive Lizenzvereinbarung für OCU400 in Korea – eine zusätzliche Einnahmequelle.
Der Auslauf der Lock-up-Frist könnte kurzfristig für zusätzlichen Verkaufsdruck sorgen. Langfristig hängt die Bewertung davon ab, ob Ocugen seine klinischen Meilensteine erreicht und rechtzeitig frisches Kapital auftreiben kann.
Ocugen-Aktie: Kaufen oder verkaufen?! Neue Ocugen-Analyse vom 09. März liefert die Antwort:
Die neusten Ocugen-Zahlen sprechen eine klare Sprache: Dringender Handlungsbedarf für Ocugen-Aktionäre. Lohnt sich ein Einstieg oder sollten Sie lieber verkaufen? In der aktuellen Gratis-Analyse vom 09. März erfahren Sie was jetzt zu tun ist.
Ocugen: Kaufen oder verkaufen? Hier weiterlesen...













